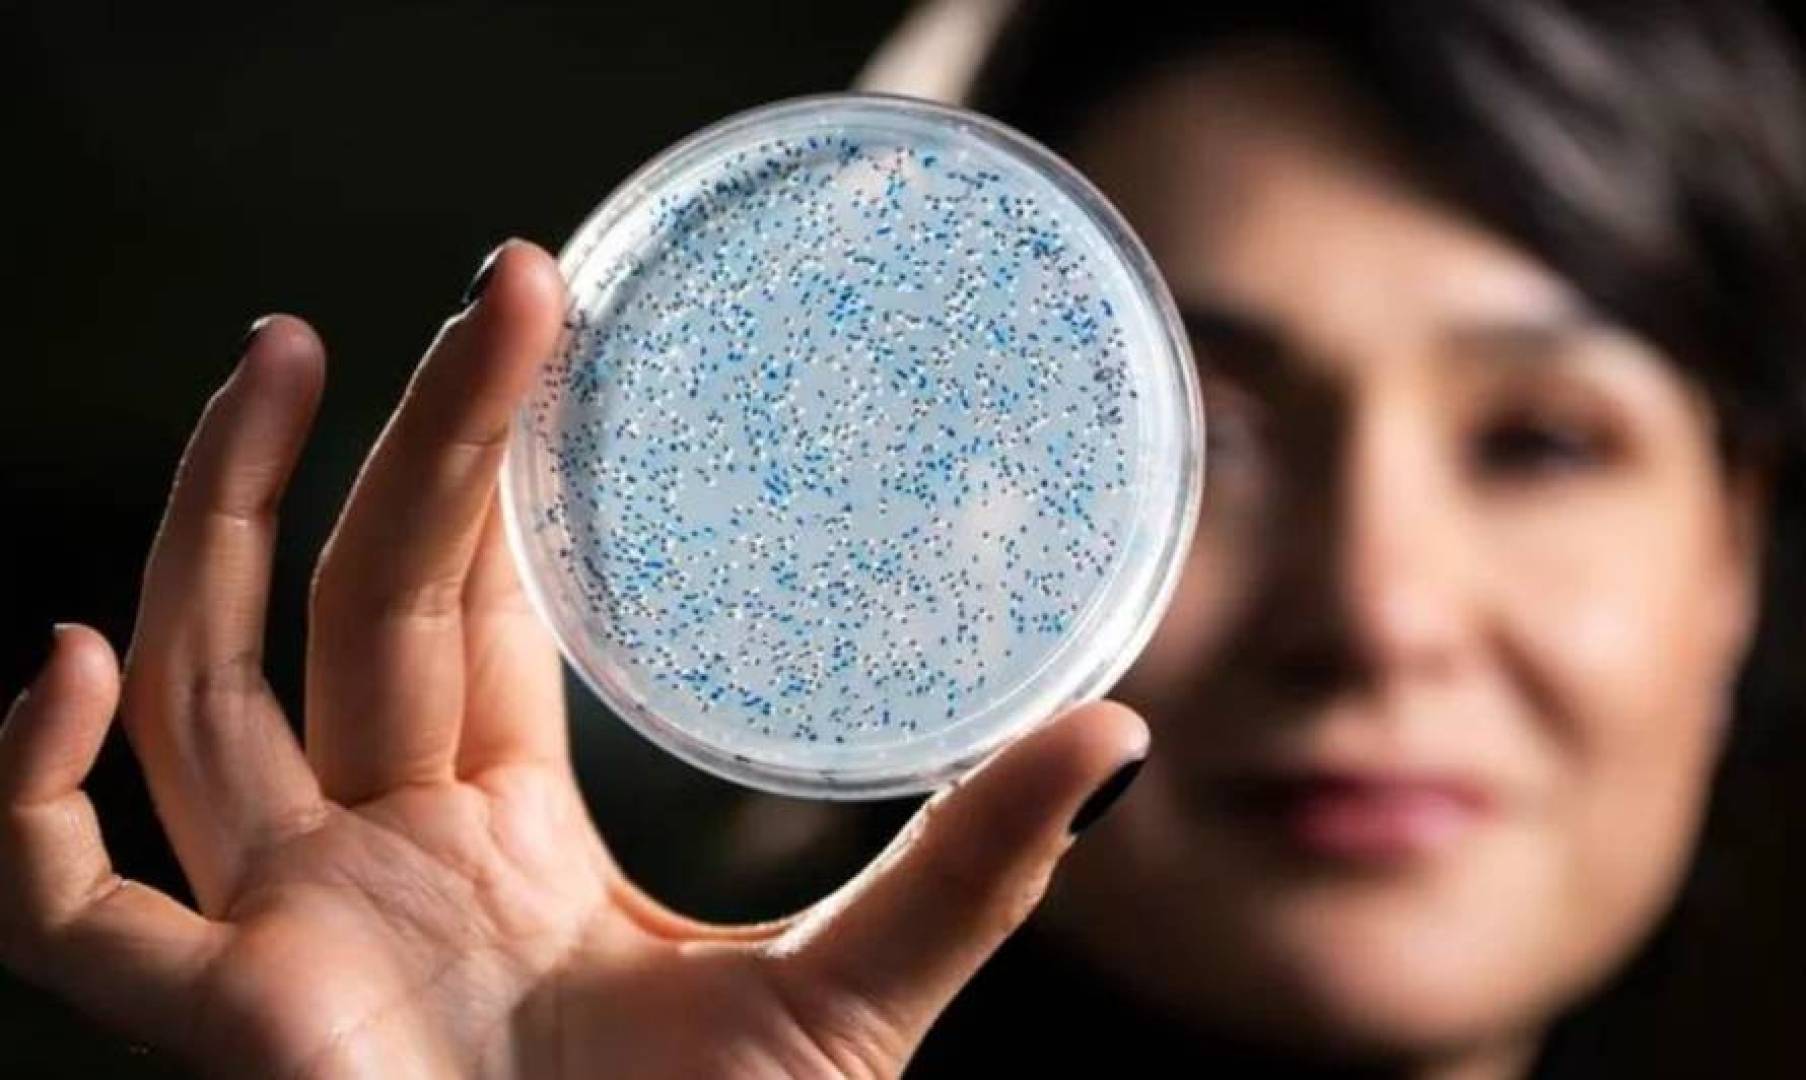

توصل علماء من جامعة لييج إلى آلية جديدة قد تُحدث تحولا في علاج السرطان، حيث تمكنوا من جعل الأورام السرطانية "مرئية" لجهاز المناعة، مما يسمح بمهاجمتها بشكل فعال.
وبحسب الدراسة المقبولة للنشر في مجلة Nature Communications، فإن تعطيل عملية دقيقة داخل الخلايا السرطانية يمكن أن يكشفها أمام الجهاز المناعي .
كيف تختبئ الخلايا السرطانية من المناعة؟
تعتمد الخلايا السرطانية على نظام عالي الدقة لإنتاج البروتينات، مما يساعدها على التخفّي من جهاز المناعة.
ويؤدي تعديل خاص في جزيئات الحمض النووي الريبوزي الناقل، يتم بواسطة إنزيم KEOPS، دورا أساسيا في هذه العملية، خصوصا في أورام مثل الميلانوما.
ماذا يحدث عند تعطيل هذه الآلية؟
عند تعطيل تعديل tRNA داخل الخلايا السرطانية:
تتراكم بروتينات غير مطوية بشكل صحيح
يعتبرها الجسم إشارة خطر
يتم تنشيط جهاز المناعة كما يحدث عند العدوى الفيروسية
وبالتالي، تبدأ الخلايا التائية بالتسلل إلى الورم ومهاجمته.
تحويل الأورام من "باردة" إلى "ساخنة"
أظهرت التجارب ما قبل السريرية أن تعطيل هذا المسار يؤدي إلى:
تحويل الأورام "الباردة" (التي لا تستجيب للمناعة) إلى "ساخنة"
زيادة تسلل الخلايا المناعية إلى داخل الورم
إبطاء نمو السرطان بشكل ملحوظ
وهذا يمثل تقدما مهما في علاج الأورام المقاومة للعلاج المناعي التقليدي.
نهج مختلف عن العلاجات الحالية
يختلف هذا الاكتشاف عن طرق العلاج المناعي التقليدية، التي تركز على تحفيز جهاز المناعة مباشرة.
بدلًا من ذلك، يعتمد النهج الجديد على:
جعل الخلايا السرطانية نفسها أكثر قابلية للاكتشاف
كشف "نقاط الضعف" داخل الورم
رأي العلماء في الاكتشاف
أوضح الباحث بيير كلوز أن هذا النهج يمثل طريقة جديدة كليًا لتنشيط المناعة ضد السرطان، حيث يؤدي تراكم البروتينات المعيبة إلى إطلاق استجابة مناعية قوية مشابهة للاستجابة ضد الفيروسات.
آفاق مستقبلية للعلاج
يرى العلماء أن هذا الاكتشاف قد يفتح المجال أمام:
تطوير علاجات جديدة للأورام المقاومة
تحسين فعالية العلاجات المناعية الحالية
استهداف نقاط ضعف غير مستغلة سابقا في الخلايا السرطانية
كما يشير إلى أن استقرار إنتاج البروتين داخل الخلايا السرطانية قد يكون "نقطة ضعف قاتلة" يمكن استغلالها طبيا.
يمثل هذا الاكتشاف خطوة مهمة نحو فهم أعمق لكيفية تفاعل السرطان مع جهاز المناعة، وقد يمهد الطريق لعلاجات أكثر دقة وفعالية، خاصة في الحالات التي لا تستجيب للعلاجات الحالية.